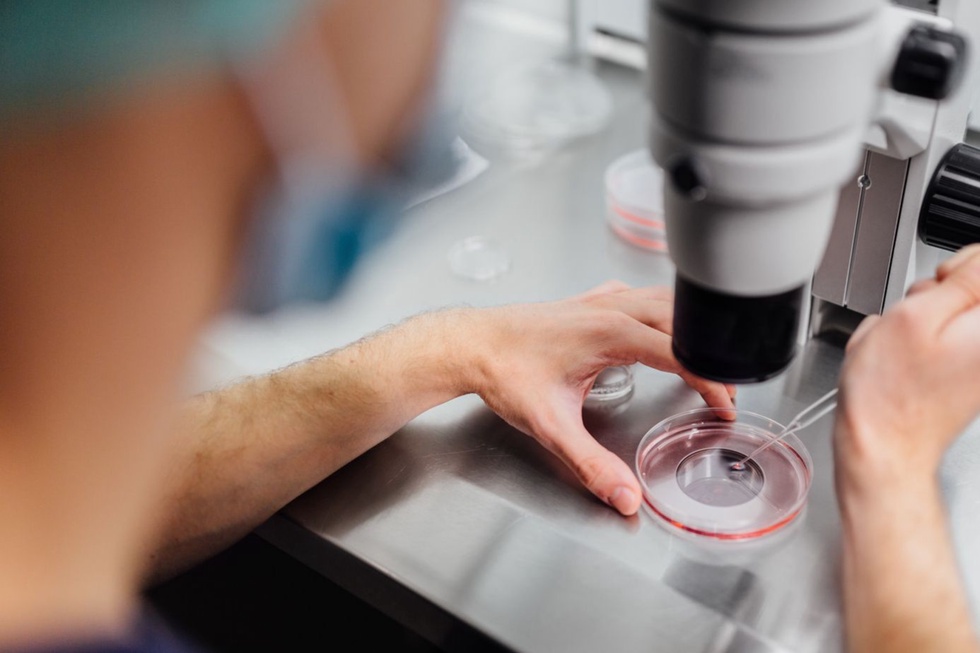

Жаҳон соғлиқни сақлаш ташкилотининг навбатдаги ҳисоботига кўра, жорий йил бошидан буён 31 мамлакатда вабо эпидемияси қайд этилди.
“Кўрсаткичлар йил сайин ошиб бораётгани хавотирли, – дейди ЖССТ раҳбари Тедрос Гебрейесус. – Масалан, ўтган йили вабога чалиниш ҳолатлари 2021 йилга нисбатан икки баравар кўпайган эди. Бу йил эса вазият янада ёмон.”
Ҳозир эпидемия ўчоқларининг катта қисми Африка мамлакатлари ҳудудига тўғри келади.
Халқаро экспертларнинг прогноз қилишича, келгусида йиллик касалланишлар сони 1,3 миллиондан 4 миллионга етиши мумкин. Бу эса 143 минг кишининг ўлимига сабаб бўлиши тахмин қилиняпти.